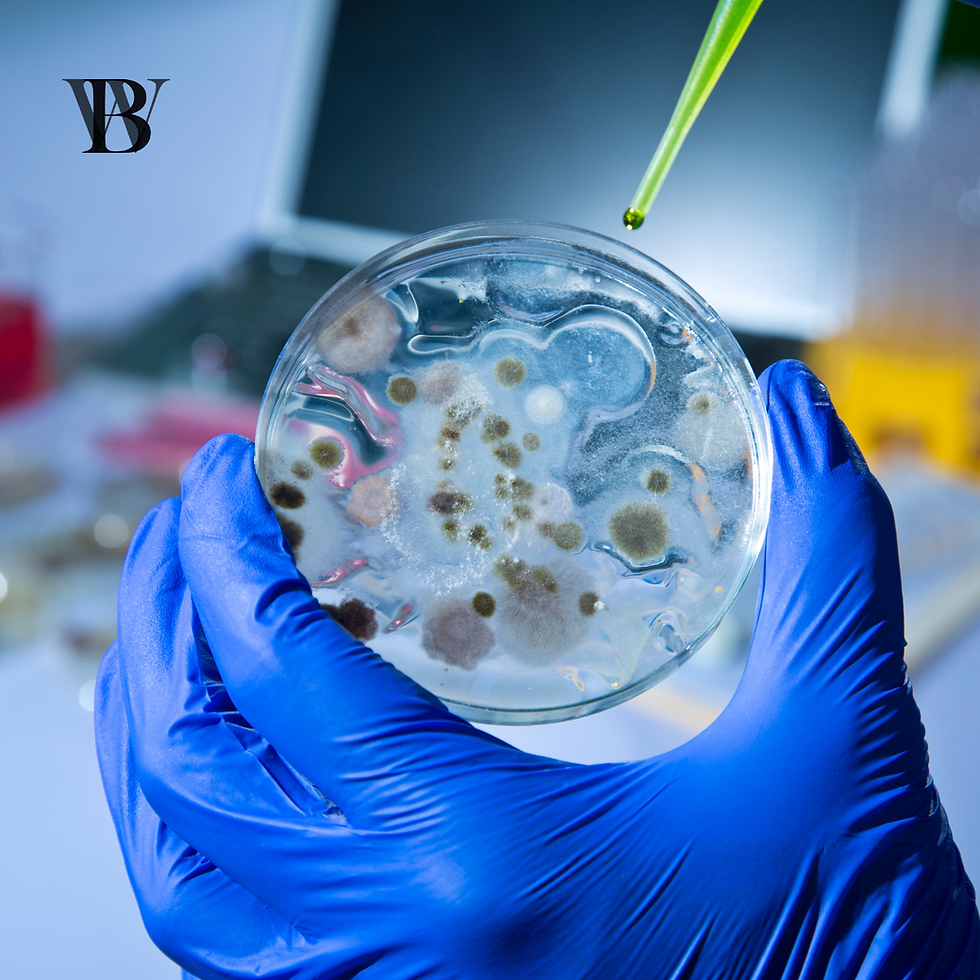
ANTIMICROBIAL PEPTIDES – The remedy to the antibiotic resistance threat?

JOB FLEXIBILITY ACCORDING TO OUR CIRCADIAN RYTHM!
- Natalia Ramírez Comet

- Nov 13, 2024
- 3 min read
Did you know that Earth’s rotation doesn’t just cause the tides – the rise and fall of the sea level twice a day – but also influences our sleep-wake cycle?

Every 24 hours, as the Earth spins, we get light from the sun when we’re facing it. It’s this sunlight that controls our sleepiness by stimulating special photosensitive cells in our eyes. These cells send signals to a part of the brain called the suprachiasmatic nucleus, which then tells the pineal gland to either stop or start producing melatonin. When it’s dark, melatonin (the "hormone of darkness") kicks in, helping us fall asleep. But light doesn’t just affect melatonin – it also impacts other hormones like cortisol (the stress hormone), body temperature, metabolism, cognitive functions, and even our eating patterns.
In other words, our bodies have these "solar-powered" mechanisms that run on a 24-hour cycle, known as the circadian rhythm (from Latin: "circa" meaning "about" and "diem" meaning "day"). But you've probably noticed that even among people from the same city, with the same exposure to sunlight, some can’t stop yawning at dinner (early birds), while others aren’t fully awake until their first cup of coffee in the morning (night owls). So why is that?
It turns out that our genetics, environment (like exposure to artificial light, lifestyle) and even our age play a role in shaping our personal sleep preferences, also known as our chronotype. And this can change throughout life. For instance, as we age, the lens in our eyes thickens, which filters out more blue light, something that could impact our sleep patterns. Hormones and lifestyle changes also play a big part.
But what’s the evolutionary reason behind having different chronotypes? One theory is that night owls might be descendants of ancestors who stayed up to watch over the group at night. While that’s a fun idea – and many animals do have sentinels to protect the group while others sleep – it was probably more of a group effort, with everyone taking turns staying alert. In fact, a study on the Hadza, a group of hunter-gatherers who live without artificial light, shows that different people experience moments of shallow sleep or wakefulness at different times throughout the night. This variation in sleep patterns might have evolved to help keep the group safe during vulnerable nighttime hours.
Are chronotypes an advantage in today’s world? Not really—in fact, they can be a disadvantage, largely due to our rigid work culture. If you work a typical 9-to-5 job, you're expected to stick to a fixed schedule, which can be particularly challenging for night owls who struggle with early mornings. Even in roles that don’t involve direct interaction with the public, there's often an expectation to be available during regular business hours, leaving little room for flexibility. Only in rare jobs, where minimal interaction with others is required, might you have the freedom to align your work schedule with your natural chronotype. So, if you’re a night owl, you’re likely at a disadvantage in today’s world.
You might have heard about the popular book called “The 5am Club“ that promotes the idea of waking up early to invest time in your morning routine and focus on your well-being before starting the day. While it might be a great concept, the title doesn’t suit all chronotypes. Not everyone is wired for a 5 a.m. wake-up, and that’s perfectly fine! People have different natural rhythms, and productivity doesn’t have to rely on being an early riser.